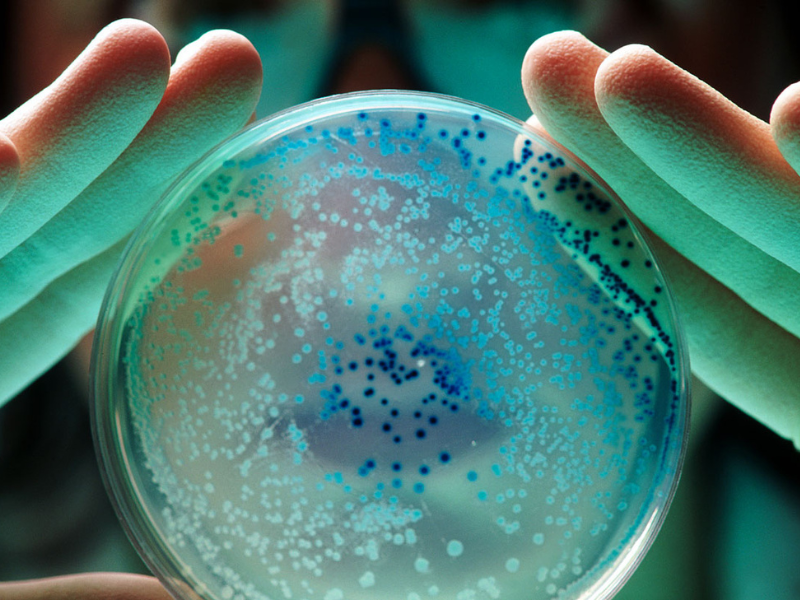
Super Bacteria 800x600 1

To eliminate drug-resistant bacteria, “last-resort” antibiotics borrow a method from Medusa’s playbook: petrification.
New high-resolution microscope pictures show that a class of antibiotics called polymyxins crystallizes bacteria’s cell membranes. The honeycomb-shaped crystals that form transform the microorganisms’ normally supple skins of fat molecules right into thin brittle sheets, researchers report October 21 in Nature Communications. The bacteria perish when the petrified membranes break.
The finding was a total shock, claims Sebastian Hiller, a structural biologist at the University of Basel in Switzerland.
Hiller, Selen Manioğlu (biophysicist), and their colleagues had been utilizing the antibiotics as a control for a different experiment. When the scientists switched on their microscopes, “we saw these waffles,” Hiller says. “I quickly recognized, wow, this must be something unique.”.

Polymyxin antibiotics like colistin were found in the 1940s and are now utilized as a potent last-ditch defense facing bacteria that have developed resistance to most other drugs. Researchers have already recognized that polymyxins, in some way, interfere with bacterial cell membranes. Nobody had envisioned a scenario like the “waffles” the group discovered.
In the new research, Hiller and colleagues subjected bits of the cell membrane from Escherichia coli to varying colistin concentrations. Imaging with atomic force microscopy exposed that crystals developed at the minimum concentrations needed to eliminate the bacteria. Colistin-resistant strains subjected to the drug did not develop crystals.
The results suggest that polymyxins work by organizing the cell membrane into a crystalline structure that makes it brittle and vulnerable. “That is something that has not even remotely been hypothesized up until now,” says Markus Weingarth, a biochemist at Utrecht University in the Netherlands. The latter was not directly involved in the work. “It is an extremely crucial study. I would certainly even claim it is an innovation”.
How specifically polymyxins crystallize cell membranes continues to be unclear. That is a trouble since some bacteria have built a resistance to polymyxins and are becoming more prevalent (SN: 5/27/16; SN: 10/30/90). With more research studies like this one to help show how the drugs operate, researchers can effectively modify the antibiotics to be more effective, Weingarth claims.
Hiller hopes that this first glance at polymyxins’ petrifying powers will aid researchers in fighting antibiotic resistance.
“Understanding these principles will absolutely bring many suggestions– and the potential to produce new drugs,” Hiller says.
Read the original article on Science News.
Read more: Investigators Look Into Combating Tumours With Magnetic Bacteria.